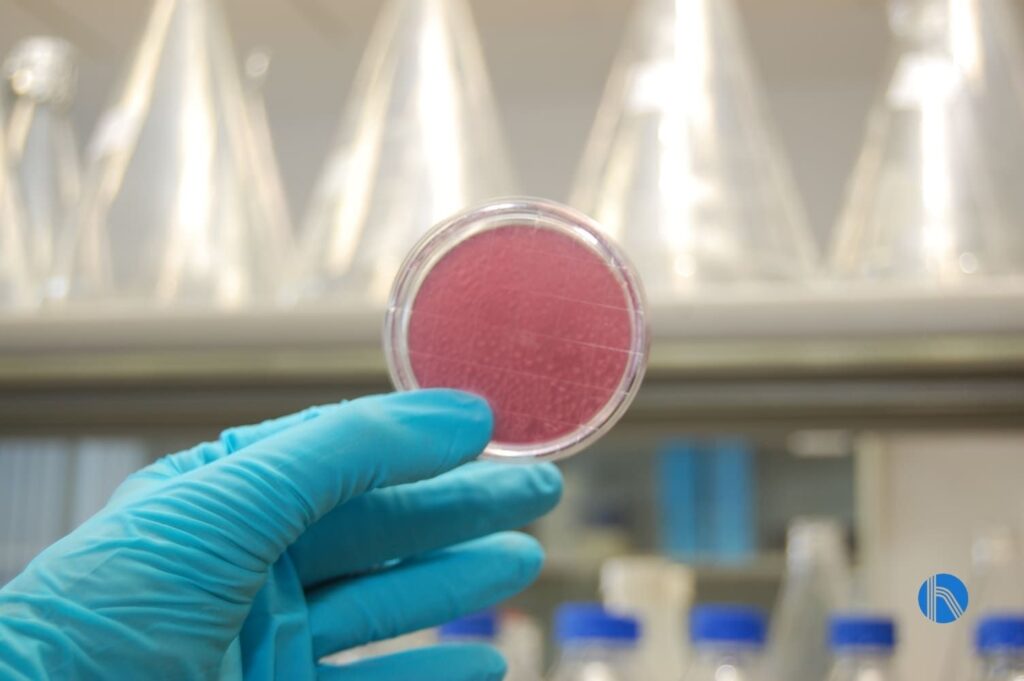
Chemical service for industrial water

J. Huesa Water Technology is a company with over 50 years of experience in comprehensive water cycle management. We offer a range of engineering solutions, including custom manufacturing, installation, commissioning and O&M for industrial water treatment plants, drinking water treatment, purification and reuse.
Within the after-sales service structure, the chemical product area plays an essential role in ensuring the performance, reliability and optimization of treatment plants installed in industrial environments. This department integrates engineering, advanced diagnostics and continuous technical monitoring, providing a differential value compared to conventional chemical suppliers.
In this article, we aim to describe the seven key services provided by this area, which are designed to maximize efficiency, reduce costs and protect an essential resource: industrial or process water.
Water analysis for chemical treatment planning
The first step in ensuring effective chemical treatment is a thorough analysis of the quality of the water supplied to the process. J. Huesa has proven experience in data collection, characterization and testability.
These analyses enable us to:
● Determine key parameters such as conductivity, pH, suspended solids, hardness, metal content, silica, organic matter, among others.
● Identify possible causes of scaling, corrosion or biological growth.
● Define the baseline on which to project the most appropriate chemical dosage.
This prior knowledge is essential for designing a customized chemical treatment programmed to avoid generic interventions that may be ineffective or inefficient.
Taking samples for analytical control
Customised chemical treatment design
With the analytical data previously obtained, the next step is to develop a chemical treatment design adapted to the actual conditions of the industrial plant. This design includes the selection of the appropriate chemicals (corrosion inhibitors, anti-scalants, biocides, cleaning agents, etc.), their dosage, the optimum injection point and the monitoring strategy.
In this context, at J. Huesa we apply an engineering approach to provide the optimum technical, economic and environmental solutions for process water treatment.

Real case study: JH0100 dosage calculation software for RO
Customised chemical treatment offers multiple advantages for the customer:
- Better control of critical variables (such as scaling or corrosion),
- Reduction in unplanned downtime,
- Optimisation of resources (water, energy, chemicals) and,
- Extension of asset life.
Water improvement and savings study
In industry, water is a strategic resource and every litre optimized is important. As part of this service, J. Huesa’s chemical product division carries out a detailed study of industrial water flows, identifying areas for optimization in water supply quality, potential regeneration, reduction of waste, improvement of conversion in reverse osmosis systems, etc.
Thanks to this analysis, measures can be proposed that involve:
● Improved water recovery in membrane systems.
● Reduction in gross water consumption thanks to better chemical treatment and tighter control.
● Savings in water, energy and chemical costs by optimising the water circuit and reducing pollution, scaling and corrosion loads.
Asesoramiento de mantenimiento y operación
Good chemical treatment design must be complemented by proper preventive maintenance and operation to ensure its effectiveness over time. In this regard, the service offers ongoing technical advice on:
● Monitoring of relevant parameters: temperature, conductivity, pH, flow rates, differential pressure, etc.
● Operational recommendations to optimise chemical performance: dosage adjustments, cleaning times, shutdown scheduling, operating habits.
● Training plant personnel to understand the effects of chemical treatment on equipment and how to detect deviations. This advice is integrated into the customer service culture that J. Huesa promotes through personalized attention and active listening.
● The result: greater operational reliability, fewer incidents and more effective preventive maintenance.
Osmosis standardisation and cleaning frequency study
Plants that incorporate reverse osmosis units or membrane systems are particularly sensitive to water quality, scaling, biofilm formation and membrane degradation. This specific service includes:
● Evaluation of membrane operating conditions: recovery, rejection, differential pressure, permeate, rejection.
● Definition of cleaning (CIP — cleaning in place) and flushing protocols, according to the nature of the fouling detected.
● Study of the optimal cleaning frequency, with the aim of maximizing the useful life of the membranes, minimizing downtime and reducing the chemical and water consumption associated with cleaning.
● This approach minimizes the risk of fouling or blockages and helps the membranes to operate within their optimal parameters for longer.
Laboratory specialising in membrane autopsies
For industrial treatment plants, when incidents occur with membranes (damaged rejection, high pressure, poor quality permeate), the best strategy is to investigate the cause by performing a membrane autopsy.
In this service, J. Huesa’s expert chemical product laboratory performs detailed analyses that include:
● Identification of the nature of the dirt or fouling: type of scales, biofouling, organocolloids, metals, silicates, etc.
● Selection of customised cleaning protocols based on the diagnosis.
● Validation of results and optimization of cleaning to restore membrane performance.
This level of advanced analysis is key for large plants where the cost of membrane replacement is high, and the impact of downtime is significant. This approach maximizes asset value and reduces TCO (Total Cost of Ownership).

Actual case of cartridge filter autopsy in an RO system.

Real case autopsy of SDI membrane
Preparation of Chemical Treatment Monitoring Reports and Optimization Recommendations
Finally, the chemical division prepares periodic reports covering:
● Evolution of key parameters for chemical treatment (dosage, consumption, performance indicators).
● Comparative analytical results before/after implementation of the chemical program.
● Identification of deviations, trends, and improvement opportunities.
● Recommendations to optimize the chemical program: adjustments, new treatment stages, consumption reduction, and performance improvement.
This continuous monitoring service provides the industrial client with a technical-operational document that supports decision-making, enhances transparency in after-sales service, and strengthens trust in J. Huesa’s offering.
Conclusión
Water as an industrial resource must be managed not only from a mechanical or civil engineering perspective, but also from a chemical, operational and continuous service perspective. At J. Huesa, the chemical product area of the after-sales service is positioned as a strategic ally for the industry: not only to resolve incidents, but also to anticipate them, optimise resources, reduce costs and guarantee the sustainability of the asset.
With the integration of analytical services, chemical design, savings studies, operational advice, membrane protocols, a specialised laboratory and continuous monitoring, the company offers a high added-value solution that reinforces its leadership in industrial water treatment.
In an environment where regulatory pressure, water scarcity and operational demands leave no room for error, having a technical partner such as J. Huesa capable of rigorously addressing chemical treatment is a decisive advantage.






